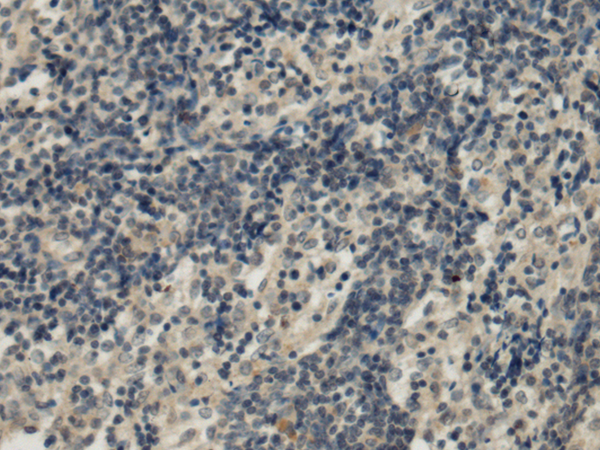

中文名稱: 兔抗PLTP多克隆抗體
英文名稱: Anti-PLTP rabbit polyclonal antibody
別 名: BPIFE; HDLCQ9
相關(guān)類別: 一抗
儲 存: 冷凍(-20℃)
宿 主: Rabbit
抗 原: PLTP
反應(yīng)種屬: Human, Mouse
標 記 物: Unconjugate
克隆類型: rabbit polyclonal
技術(shù)規(guī)格
|
Background: |
The protein encoded by this gene is one of at least two lipid transfer proteins found in human plasma. The encoded protein transfers phospholipids from triglyceride-rich lipoproteins to high density lipoprotein (HDL). In addition to regulating the size of HDL particles, this protein may be involved in cholesterol metabolism. At least two transcript variants encoding different isoforms have been found for this gene. |
|
Applications: |
ELISA, WB, IHC |
|
Name of antibody: |
PLTP |
|
Immunogen: |
Fusion protein of human PLTP |
|
Full name: |
phospholipid transfer protein |
|
Synonyms: |
BPIFE; HDLCQ9 |
|
SwissProt: |
P55058 |
|
ELISA Recommended dilution: |
5000-10000 |
|
IHC positive control: |
Human esophagus cancer and Human prostate cancer |
|
IHC Recommend dilution: |
100-200 |
|
WB Predicted band size: |
55 kDa |
|
WB Positive control: |
K562 and 293T cell lysates |
|
WB Recommended dilution: |
500-2000 |

購物車
幫助
021-54845833/15800441009
